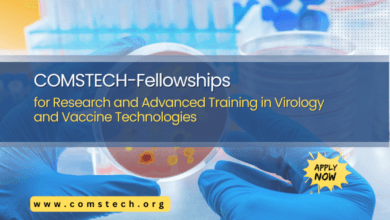

comstech
Prof. Dr. M. Iqbal Choudhary, Coordinator General COMSTECH met with the honourable Lt. Gen. Naweed Zaman
, Rector of National University of Sciences and Technology (NUST), Islamabad, Pakistan on 16th June 2020. The dignitaries discussed opportunities…
أكمل القراءة »H.E. Prof. Dr. M. Iqbal Choudhary, Coordinator General COMSTECH had an online meeting with H.E. Ambassador Askar Mussinov, Assistant Secretary General (S&T), Organization of Islamic Cooperation (OIC)
H.E. Prof. Dr. M. Iqbal Choudhary, Coordinator General COMSTECH had an online meeting with H.E. Ambassador Askar Mussinov, Assistant Secretary…
أكمل القراءة »June 17, 2020: Coordinator General COMSTECH H. E. Prof. Dr. M. Iqbal Choudhary met with H. E. Mr. Muhammad Azam Khan Swati
Coordinator General COMSTECH H. E. Prof. Dr. M. Iqbal Choudhary met with H. E. Mr. Muhammad Azam Khan Swati, Minister…
أكمل القراءة »June 19, 2020: Dr. Abdur Rashid, Director, DRAP and Dr. Ghazna Khalid Siddiqui MNA
Dr. Abdur Rashid, Director, DRAP and Dr. Ghazna Khalid Siddiqui MNA and Member, Task Force of Ministry of Science and…
أكمل القراءة »المؤتمر الدولي الثاني لعلم الفطريات في منطقة الشرق الأوسط وشمال إفريقيا (ICM-2018)
نظمت الجمعية العربية للمحافظة على الفطريات (ASFC) ، والكومستيك ، والنقابة المصرية للمهن العلمية ، والأكاديمية الوطنية للعلوم وتكنولوجيا البحث…
أكمل القراءة »COMSTECH International Webinar on Light and Polymers by Prof. Dr. Yusuf Yagci
Date: 10th September 2020 Time: 03:00 pm Pakistan Standard Time; 02:00 pm Gulf Standard Time; 10:00 am Greenwich Mean Time
أكمل القراءة »-
غير مصنف

Weekly Updates on Covid-19
COVID Updates Jan 21 – 27, 2020COVID Updates Jan 14 – 20, 2020COVID Updates Jan 07 – 13, 2020COVID Updates…
أكمل القراءة » -
الأحدا

Intellectual Property for Scientists
Jointly organized byOIC Standing Committee on Scientific and Technological Cooperation (COMSTECH),International Center for Chemical and Biological Sciences (ICCBS),Sindh Innovation, Research,…
أكمل القراءة »